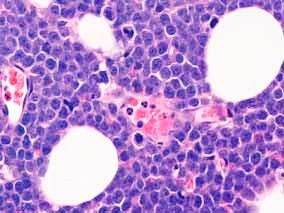
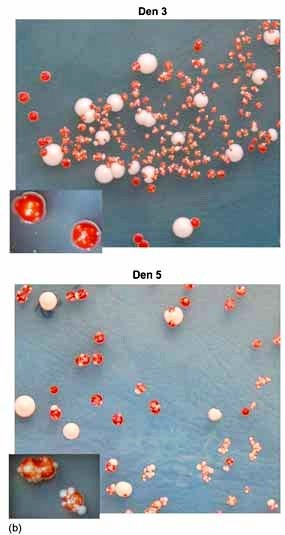

Konference: 2007 XIV. Jihočeské onkologické dny
Kategorie: Maligní lymfomy a leukémie
Téma: Postery
Číslo abstraktu: 033p
Autoři: prof. RNDr. Jana Šmardová, CSc.; Mgr. Diana Grochová; MUDr. Pavel Fabián, Ph.D.; MUDr. Mojmír Moulis; Prof. RNDr. Jan Šmarda, CSc.; RNDr. Barbora Ravčuková; RNDr. Iva Falková; MUDr. Jana Vaňková; MUDr. Ingrid Vášová
Abstrakt
Burkittovy lymfomy (BL) patří k rychle rostoucím vysoce agresivním nehodgkinským lymfomům (NHL). Charakteristickým molekulárním markerem BL je vysoká exprese protoonkogenu c-myc, která nejčastěji vyplývá z translokace t(8;14)(q24;q32), méně často z translokace t(2;8)(p12;q24) nebo t(8;22)(q24;q11). K častým genetickým změnám u BL rovněž patří aberace nádorového supresoru p53. Protein p53 je sekvenčně specifický transkripční faktor, který se váže na DNA a řídí expresi mnoha svých cílových genů jako odpověď na buněčný stres. Pro analýzu aberací p53 lze použít různé metody, například imunohistochemickou analýzu, westernový přenos, sekvenování DNA, fluorescenční in situ hybridizaci a také funkční analýzu separovaných alel v kvasinkách (FASAY). Všechny tyto metody jsme použili u prezentovaného případu BL k podrobné analýze p53. Třiapadesátiletý muž byl operován v dubnu 2006 s podezřením na difúzní velkobuněčný B-lymfom s rozsáhlým postižením dutiny břišní. Byl postižen žaludek, okolní uzliny, tkáně, kostní dřeň a CNS. Diagnóza byla uzavřena jako Burkittův lymfom, klinické stadium IVB, s pozitivitou t(8;14) detekovanou fluorescenční in situ hybridizací. Intenzivní léčbou kombinovanou imunochemoterapií bylo dosaženo kompletní remise, která trvá dosud. V buněčných jádrech nádorové tkáně pacienta jsme imunohistochemickou analýzou detekovali vysokou hladinu proteinu p53. Westernovým přenosem jsme potvrdili vysokou hladinu proteinu p53 v nádorových buňkách a zároveň jsme zjistili, že molekulová hmotnost proteinu p53 nádorových buněk je vyšší než molekulová hmotnost standardní varianty p53. Také molekulová hmotnost produktu PCR, odpovídajícího cDNA p53 z nádorové tkáně, byla vyšší než molekulová hmotnost amplifikátu standardní varianty p53. Funkční analýza v kvasinkách jednoznačně prokázala expresi nefunkční varianty p53, postrádající transkripčně aktivační schopnost, přičemž kvasinkové kolonie vykazovaly velmi neobvyklý fenotyp. Sekvenováním cDNA připravené z nádorové tkáně jsme v genu p53 detekovali duplikaci fragmentu vymezeného kodóny 77 a 87 o velikosti 30 pb (g.12155_12184dup30). Fluorescenční in situ hybridizací jsme neprokázali ztrátu heterozygotnosti p53 delecí p53 specifického lokusu 17p13.
Úvod
Burkittovy lymfomy (BL) patří k rychle rostoucím
vysoce agresivním nehodgkinským lymfomům (NHL). Představují asi 1
až 2% lymfomů dospělé populace v západní Evropě a Spojených
státech. Charakteristickým molekulárním markerem BL je vysoká
exprese protoonkogenu c-myc, která je nejčastěji důsledkem
translokace t(8;14)(q24;q32), méně často translokace
t(2;8)(p12;q24) nebo t(8;22)(q24;q11). Vysoká hladina proteinu
c-Myc buňkám poskytuje konstitutivní proliferační signál. c-Myc ale
může také indukovat apoptózu aktivací p53 přes p14ARF. Některé
práce naznačují, že právě vyřazení signální dráhy p14ARF-MDM2-p53
by mohlo představovat klíčový druhý zásah při vývoji BL. Významný
podíl případů BL skutečně nese bodovou mutaci v genu kódujícím
nádorový supresor p53 a jiná poškození dráhy p14ARF-MDM2-p53
(Drexler et al. 2000, Lindstrom and Wiman 2002, Wilda et al.
2004).
Nádorový supresor p53 je sekvenčně specifický
transkripční faktor, který se váže na DNA a řídí expresi mnoha
svých cílových genů jako odpověď na buněčný stres a podílí se na
regulaci řady důležitých buněčných procesů jako jsou buněčný
cyklus, apoptóza, senescence a genomová stabilita (Levine et al.,
2006). Inaktivace p53 vyplývající z různých genetických aberací je
jednou z nejčastějších událostí během kancerogeneze. Více než 50%
všech lidských nádorů nese mutaci v genu p53. Více než 80% z nich
jsou bodové záměny, tj. mutace měnící smysl kodónu, které vedou k
syntéze stabilního proteinu p53 standardní velikosti (Olivier et
al., 2002, Soussi et al. 2006). Pro detekci aberací p53 bylo
vyvinuto několik různých metodických přístupů. (1) Ve zdravých
buňkách je hladina proteinu p53 udržována degradací
zprostředkovanou proteinem MDM2. Exprese genu MDM2 je
regulována p53, takže MDM2 představuje zpětnovazebnou regulační
smyčku (Yang et al. 2004). Nefunkční p53 nemůže indukovat expresi
MDM2 a je proto stabilizován v buněčných jádrech. Vysoká hladina
proteinu p53 může být detekována buď na tkáňových řezech
imunohistochemickou analýzou nebo na nitrocelulózové membráně po
proteinové elektroforéze a westernovém přenosu. (2) Popsáno bylo
několik různých molekulárních analýz, které detekují změny v
nukleotidové sekvenci geonomové DNA, mRNA nebo cDNA. Mezi nimi
přímé sekvenování DNA je tou nejspolehlivější metodou detekce
mutací p53. Ovšem citlivost této metody je spíše omezená, zvláště
tam, kde je nádorová tkáň kontaminována nenádorovými buňkami. (3)
Funkční metody mohou analyzovat některé biologické vlastnosti
proteinu p53. Funkční analýza separovaných alel v kvasinkách
(„functional analysis of separated alleles in yeast“ - FASAY) je
založena na měření transaktivačních schopností proteinu p53.
Protein p53 je odvozen z nádorové tkáně pomocí RT-PCR a exprimován
v transformovaných kvasinkových buňkách, které nesou reportérský
gen ADE2 s předřazenou sekvencí RGC, na kterou se p53 váže (Ishioka
et al. 1993, Flaman et al. 1995). Aktivita proteinu p53 se určuje
jednoduše podle zbarvení kvasinkových kolonií rostoucích na
selekčním médiu. Exprese funkčního p53 vede k tvorbě bílých
kolonií, zatímco nefunkční, mutantní p53 způsobuje vznik červených
kolonií. (4) Podle klasické hypotézy „dvou zásahů“ musí u většiny
nádorových supresorů dojít k inaktivaci obou alel. Tento jev byl
opakovaně prokázán také u p53 (Trkova et al. 2003). Nejčastějším, i
když ne výlučným mechanismem ztráty heterozygotnosti genu p53 je
ztráta p53 specifického lokusu na chromozomu 17 (17p13.1). Vhodnou
metodou pro detekci této aberace je fluorescenční in situ
hybridizace (FISH) s využitím p53 specifické sondy.
Využili jsme všechny výše zmíněné metody k
charakterizaci neobvyklé mutace p53, kterou jsme detekovali v
nádorové tkáni u pacienta s Burkittovým lymfomem. Prokázali jsme
zvýšenou molekulovou hmotnost a nefunkčnost proteinu p53 u tohoto
případu plynoucí z duplikace fragmentu o velikosti 30 párů bazí:
g.12155_12184dup30. Duplikovaná byla část kódující sekvence
vymezená kodóny 77 a 87.
Materiál a metody
Popis případu
Třiapadesátiletý muž byl operován v dubnu 2006 s
podezřením na difúzní velkobuněčný B-lymfom s rozsáhlým
postižením dutiny břišní. Byl postižen žaludek, okolní uzliny,
tkáně, kostní dřeň a CNS. Diagnóza byla uzavřena jako klasický
Burkittův lymfom, klinické stadium IVB, s translokací t(8;14)
detekovanou fluorescenční in situ hybridizací. Intenzivní
léčbou kombinovanou imunochemoterapií bylo dosaženo kompletní
remise, která trvá dosud.
Histopatologický nález
Drobné excize obsahovaly tukovou tkáň, která
byla difúzně infiltrovaná neoplastickou populací poměrně
uniformních lymfoidních buněk střední velikosti. Buňky měly
okrouhlá nebo polygonální jádra většinou se 2-3 zřetelnými malými
jadérky při periferii, cytoplazma byla bazofilní. Buňky byly vysoce
mitoticky i apoptoticky aktivní. Četné byly také makrofágy s
fagocytovanými apoptotickými tělísky, místy tvořící obraz
„hvězdného nebe“ (obr. 1). Součástí infiltrátu byla i příměs
velmi malého množství reaktivních malých kulatých T lymfocytů (cca
1-2%). Nádorové buňky byly imunohistochemicky pozitivní na CD10,
CD20, CD45, CD79a, MUM1, Bcl6 a fokálně slabě také na CD138;
negativní na CD3, CD5, CD23, CD30 a Bcl-2. Proliferační aktivita
dle Ki67 byla vysoká, asi 95%.
FASAY
FASAY byla provedena podle dříve popsaného
postupu (Flaman et al., 1995; Smardova et al. 2001). Celková RNA
byla purifikována pomocí RNeasy Mini Kit (Qiagen), cDNA
syntetizována systémem SuperScript II (Invitrogen) s využitím oligo
(dT)12 jako primeru. PCR byla provedena s primery P3
(5’-CCT-TGC-CGT-CCC-AAGCAA-TGG-ATG-AT-3’), P4
(5’-ACC-CTT-TTT-GGA-CTT-CAG-GTG-GCT-GGA-GT-3’) a Pfu DNA
polymerázou (Stratagene). Kvasinkové buňky byly transformovány
produktem PCR, linearizovaným vektorem pSS16 a nosičovou DNA
(Invitrogen) s využitím octanu litného (Ishioka et al. 1993).
Transformované buňky byly kultivovány na minimálním agarovém médiu
bez leucinu a s nízkým obsahem adeninu (5 µg/ml). Kultivace
probíhala ve 35°C po dobu 3 dnů, následně v pokojové teplotě po
dobu dalších 2 až 3 dnů.
Izolace plasmidové DNA z kvasinek a sekvenování
DNA
Plasmidy nesoucí cDNA p53 byly extrahovány z
transformovaných kvasinkových buněk, které byly lyzovány lytickými
enzymy Trichoderma harzianum (Sigma-Aldrich). Centrální část
genu p53 byla amplifikována PCR s využitím primerů P3 a P4 a Taq
polymerázy (Invitrogen). Produkt PCR byl extrahován z gelu pomocí
MinElute PCR Purification Kit (Qiagen) a sekvenován pomocí
BigDyeTerminator v3.1 Cycle Sequencing Kit (Applied Biosystems) a
sekvenátoru ABI PRISM 310 (Applied Biosystems).
Imunohistochemická analýza
Endogenní peroxidázová aktivita byla blokována
3% hydrogen peroxidem v metanolu po dobu 10 min. Demaskování
epitopu bylo provedeno v citrátovém pufru pH 6,0 (Dako Denmark A/S)
ve 121°C po dobu 4 min. p53 specifická protilátka DO-7 (Dako
Denmark A/S) byla ředěna 1:2000 a aplikována přes noc. Reaktivní
místa byla identifikována prostřednictvím biotinylované sekundární
protilátky konjugované s peroxidázou ABC (Vector Laboratories,
Burlingame, CA, USA), DAB (Dako Denmarks A/S) po obarvení Gillovým
hematoxylinem.
Westernový přenos
Tkáně byly lyzovány v pufru obsahujícím 150 mM
NaCl, 50 mM NaF, 50 mM Tris (pH 8,0), 5 mM EDTA, 1% NP40 a 1 mM
inhibitor fenylmetylsulfonylfluoridové proteázy v ledové lázni po
dobu 30 min. Zbytky buněk v buněčném extraktu byly odstraněny
centrifugací (17000 g, 30 min). Pro přípravu kvasničných extraktů
byly kolonie kvasinkových buněk inokulovány v médiu YPDA a
kultivovány do dosažení optické hustoty OD600 0.8 - 1.0.
Buňky byly propláchnuty ledovou sterilní vodou a lyzovány v
lyzačním pufru obohaceném o 1 objem sterilních skleněných kuliček a
promíchány vortexem každých 5 minut během následující hodiny.
Lyzáty byly následně centrifugovány (17000 g, 30 min). Koncentrace
proteinů byla stanovena podle Bradfordové. Solubilizované proteiny
byly rozděleny 10% SDS-PAGE a přeneseny na nitrocelulózovou
membránu. Pro blokování nespecifických interakcí byly membrány
promývány v 0.1% Tween 20 a 5% roztoku nízkotučného mléka v PBS po
dobu 1 hodiny. Následně byly membrány inkubovány v roztoku
protilátky anti-p53 DO-1 ve 4(C. Pro vyvolání blotů jsme používali
králičí imunoglobulin konjugovaný s peroxidázou Dako a kit ECL pro
detekci chemiluminisce (Amersham Biosciences).
Fluorescenční hybridizace in situ (FISH)
FISH jsme prováděli na tkáňových řezech
připravených z parafinových tkáňových bločků fixovaných formalinem.
Hybridizaci jsme prováděli se sondou LSIp53 specifickou pro lokus
p53 a centromerickou sondou CEP 17 (Vysis) podle instrukcí výrobce.
Obrázky byly skenovány mikroskopem Leica DMRXA2 vybaveným kamerou
CCD (COHU). Fluorescenční signály byly analyzovány softwarem Leica
Q-FISH (Leica).
Výsledky
Stanovení hladiny proteinu p53
Hladinu proteinu p53 v nádorové tkáni jsme
analyzovali dvěma způsoby. Nejprve jsme provedli
imunohistochemickou analýzu řezů z parafinových tkáňových bločků
tkáně pomocí monoklonální anti-p53 protilátky DO-7. Silnou expresi
p53 vykazovalo 95-100% jader nádorových buněk (obr. 2a).
Následně jsme potvrdili vysokou hladinu p53 v nádorové tkáni
westernovým přenosem s monoklonální protilátkou specifickou pro p53
DO-1. Tímto experimentem jsme zároveň zjistili, že v nádorových
buňkách je kromě proteinu p53 o standardní molekulové hmotnosti
přítomno také významné množství proteinu p53 s molekulovou
hmotností zřetelně vyšší (obr. 2b).
FASAY
Technikou FASAY lze určit funkční stav p53
jednoduše podle barvy kolonií transformovaných kvasinkových buněk.
Kvasinkové buňky exprimující funkční p53 tvoří na selekčním médiu
velké hladké kolonie bílé barvy, zatímco kvasinkové buňky
exprimující inaktivní p53 tvoří na tomto médiu malé hladké kolonie
červené barvy. Status p53 se určuje podle poměru červených/bílých
kolonií vzhledem k celkovému počtu kolonií rostoucích na selekčním
médiu. Červené kolonie odpovídají nádorovým buňkám s mutantním p53
a bílé kolonie odpovídají jak nádorovým tak nenádorovým buňkách s
funkčním p53. Frekvence červených kolonií vznikajících
v důsledku degradace mRNA nebo nepřesným přiřazením nukleotidů
během PCR obvykle nepřesahuje 10%, což je hranice pozadí. Kromě
toho FASAY může zachytit mutace p53, které ovlivňují transaktivační
schopnost p53 pouze částečně, např. mutace závislé na teplotě. V
těchto případech se fenotyp kvasinkových kolonií odlišuje od
standardních červených a bílých kolonií. Tyto kolonie jsou obvykle
růžové nebo dvoubarevné červenobílé a jejich velikost dosahuje
intermediární úrovně v důsledku částečné schopnosti proteinu p53
transaktivovat reportérský gen (Flaman et al., 1995, Pavlova et
al., 2003).
Prvním krokem analýzy nádorové tkáně studovaného
pacienta metodou FASAY je RT-PCR. Kvalitu a kvantitu získaného
produktu PCR rutinně testujeme agarózovou gelovou elektroforézou,
která nám v tomto případě ukázala vyšší molekulovou hmotnost
amplifikované cDNA p53 ve srovnání se standardní kontrolou (obr.
3a). Transformace kvasinkových buněk tímto produktem PCR vedla
k tvorbě bílých kolonií (6,8%), typických červených kolonií (4,0%)
a neobvyklých červených kolonií s mnohonásobnými bílými skvrnami na
svém povrchu (89,2%) (obr. 3b). Tento výslede naznačil, že
gen p53 v nádorové tkáni pacienta je postižen takovou mutací, která
umožňuje částečnou funkci p53.
Sekvenování cDNA p53
Jednou z výhod metody FASAY je, že umožňuje
detekci klonálních mutací p53 i v těch případech, kdy je frakce
nádorových buněk v analyzované tkáni příliš nízká pro přímé
sekvenování DNA. cDNA p53 odvozenou z nádorové tkáně lze izolovat z
transformovaných kvasinkových buněk a následně ji použít pro
sekvenování (Pavlova et al. 2003, Nenutil et al. 2005, Trbusek et
al. 2006). V tomto případě jsme inokulovali 4 „skvrnité“ kolonie,
které jsme kultivovali samostatně přes noc v oddělených zkumavkách
a z buněčných suspenzí jsme izolovali DNA. Purifikovaná DNA byla
následně použita pro amplifikaci cDNA p53 pomocí PCR. Agarózová
gelová elektroforéza amplifikované cDNA však ukázala, že mobilita
produktů PCR převážně odpovídá p53 o standardní molekulové
hmotnosti. Zaznamenali jsme přítomnost pouze malého množství
produktů PCR o vyšší molekulové hmotnosti, které odpovídaly
velikosti cDNA p53 získané přímo z nádorové tkáně a amplifikované
PCR (obr. 4a). Proto jsem pro hledání mutace p53
sekvenováním nepoužili cDNA izolovanou z jednotlivých
kvasinkových kolonií, ale cDNA připravenou přímo z nádorové tkáně
(obr. 3a). Mutace nalezená v sekvenci p53 měla charakter
duplikace o velikosti 30 pb (g.12155_12184dup30, GenBank) (obr.
5).
Analáza statutu p53 v kvasinkových koloniích
Každá jednotlivá kvasinková kolonie získaná
metodu FASAY reprezentuje klon produkující jednu variantu p53
odvozenou z analyzované tkáně nebo vzniklou během RT-PCR. Původ
různě velkých produktů PCR vytvořených amplifikací cDNA p53 z
jednotlivých „skvrnitých“ kolonií byl proto nejasný (obr.
4a). Abychom tuto záhadu vysvětlili, analyzovali jsme dále
status p53 v kvasinkových buňkách tvořících „skvrnité“ kolonie.
Proteinové lyzáty získané z buněk kultivovaných v růstovém médiu
jsme rozdělili SDS-PAGE a přítomnost proteinu p53 jsme vyhodnotili
westernovým přenosem prostřednictvím monoklonální protilátky
anti-p53 DO-1. Prokázali jsme však, že v každém vzorku je přítomen
pouze protein p53 o standardní molekulové hmotnosti (obr.
4b). Bylo zajímavé, že pokud byly kvasinkové buňky kultivované
v růstovém médiu vysety zpět na selekční agarovou půdu, vždy
vytvořily pouze typické velké bílé kolonie odpovídající buňkám
exprimujícím plně funkční p53.
Fluorescenční hybridizace in situ
Pro určení statutu p53 v nádorové tkáni jsme
provedli interfázovou FISH na tkáňových řezech připravených z
parafinových tkáňových bločků. Nejprve jsme sondou specifickou pro
lokus p53 analyzovali 65 buněčných jader: detekovali jsme ztrátu
jednoho signálu v 7 z nich (10,8%). Následně jsme provedli FISH se
směsí sondy specifické pro lokus p53 s centromerickou sondou CH17.
Všech 43 buněčných jader, která jsme podrobili analýze, vykazovalo
2 centromerické signály, 35 jader (81,4%) poskytlo 2 signály
specifické pro lokus p53 a 8 jader (18,6%) poskytlo pouze 1 signál
specifický pro lokus p53 (obr. 6).
Diskuse
Na rozdíl od jiných nádorově supresorových genů,
má většina mutací p53 povahu bodových nukleotidových záměn.
Substituce nukleotidů reprezentují přibližně 80% všech mutací p53
detekovaných u různých typů nádorů. Většina z nich postihuje oblast
kódující DNA vazebnou doménu p53. Podstatně méně časté jsou u p53
mutace typu inzercí, krátkých delecí a mutací vedoucích ke vzniku
předčasných terminačních kodónů. Tyto mutace navíc častěji
postihují 5’ a 3’ konec genu p53 (Hainaut and Hollstein 2000,
Olivier et al. 2004, Soussi et al. 2006, Petitjean et al. 2007). V
této práci popisujeme neobvyklou mutaci p53 nalezenou v nádorové
tkáni pacienta s Burkittovým lymfomem: duplikaci úseku vymezeného
kodóny 77 a 87 o velikosti 30 pb, umístěnou mimo oblast kódující
DNA vazebnou doménu. Provedli jsme podrobnou analýzu této mutace
několika metodickými přístupy. Imunochemické analýzy prokázaly, že
protein p53 je akumulován v nádorových buňkách ve vysoké míře, což
naznačilo přítomnost mutace v genu p53. Westernovým přenosem jsme
zjistili, že protein p53 syntetizovaný nádorovými buňkami má
zřetelně zvýšenou molekulovou hmotnost. Technikou FASAY jsme dále
prokázali, že rovněž gen kódující p53 v nádorové tkáni je neobvykle
zvětšen. Elektroforetická pohyblivost proužku reprezentujícího
produkt RT-PCR připraveného z nádorové tkáně byla zřetelně snížena
ve srovnání s pohyblivostí produktu RT-PCR standardního p53.
Sekvenováním cDNA p53 odvozené z nádorové tkáně jsme zjistili
příčinu zvýšení molekulové hmotnosti molekuly p53: duplikaci
fragmentu o velikosti 30 pb vymezeného kodóny 77 a 87. Metodou
FASAY jsme jednoznačně prokázali, že protein p53 není v nádorové
tkáni plně funkční. Frekvence pozitivních „skvrnitých“ kolonií
dosáhla 90 %, což naznačuje absenci druhé alely p53
v nádorových buňkách. FISH však neprokázala tuto formu ztráty
heterozygotnosti p53. Většina jader nádorových buněk byla zřetelně
pozitivní pro oba signály specifické pro p53. Pomocí sond
specifických pro lokus p53 a centromeru chromozomu 17 jsme
vyloučili možnost, že by nádorové buňky byly tetraploidní. Stejný
výsledek - diploidní charakter - prokázala i jiná verze FISH,
zaměřená na detekci t(8;14) (q24;q32). O osudu druhé alely genu p53
v nádorových buňkách tedy můžeme pouze spekulovat. Jedna možnost
spočívá v tom, že nemutovaná alela p53 by sice mohla být fyzicky
přítomná, a proto detekovatelná FISH, ale neexprimovaná, a proto
poskytující negativní signál při FASAY (RT-PCR). Utlumení genové
exprese může být vyvoláno geneticky (např. mutací v oblasti
promotoru) nebo epigeneticky (např. metylací promotoru). Další
možností je, že exprese druhé alely není utlumena, ale alela je
mutována takovým způsobem, který vylučuje její zachycení metodou
FASAY. Například by se mohlo jednat o mutaci v místě nasedání
primeru. A konečně nelze vyloučit ani možnost, že
v obou alelách p53 je přítomna stejná mutace. Pravděpodobnost, že
stejná mutace nastane nezávisle dvakrát, je velmi nízká, téměř
nulová. Nelze však vyloučit možnost genové konverze nebo mitotické
rekombinace.
Morfologie „skvrnitých“ kvasinkových kolonií
vzniklých při FASAY byla velmi neobvyklá. Podobně nečekané bylo i
chování kvasinkových buněk v některých dalších analýzách stavu p53.
Dosud jsme při obdobných analýzách standardně potvrzovali stejné
vlastnosti genů, resp. proteinů p53 v nádorových buňkách a
odpovídajících transformovaných kvasinkových buňkách (Smardova et
al. 2005). V prezentovaném případě měla cDNA p53 odvozená z
nádorových buněk vyšší molekulovou hmotnost než standardní cDNA
p53, avšak cDNA získaná z transformovaných kvasinkových buněk měla
standardní velikost nebo byla směsí obou těchto variant cDNA. Na
proteinové úrovni zvětšené varianty p53 nebyly přítomny v
kvasinkových buňkách vůbec. Předpokládáme, že tento jev je
důsledkem nestability inzertu v kvasinkách. Kvasinkové buňky
transformované variantou cDNA p53 obsahující duplikaci tvořily při
FASAY malé červené kolonie, což naznačuje nefunkční stav p53. Avšak
během prodloužené kultivace se morfologie původně červených kolonií
mění. Během tří dnů se na povrchu těchto kolonií začnou objevovat
malé bílé skvrny, které se během další kultivace rychle zvětšují
(obr. 3b). Předpokládáme, že tyto bílé skvrny reprezentují
subklony kvasinkových buněk, které ztratily duplikovaný fragment
DNA a obnovily funkci p53. Buňky obsahující funkční p53 získávají
růstovou výhodu, protože mohou tvořit vlastní adenin a postupně
přerůstají buňky s mutovaným p53, které jsou limitovány nízkým
obsahem adeninu v selekčním médiu (Flaman et al. 1995). Důsledkem
je pak přítomnost zvětšujících se bílých skvrn na povrchu červených
kvasinkových kolonií. Pro izolaci cDNA p53 z transformovaných
kvasinkových buněk dostačuje krátká doba kultivace v malém objemu
média. Tyto podmínky umožňují přítomnost zbytkových variant
nádorových cDNA p53, které jsme detekovali agarózovou
elektroforézou. (obr. 4a). Pro analýzu proteinu p53
produkovaného kvasinkami je potřeba buňky kultivovat ve větším
objemu média a delší dobu. Tyto podmínky postačují k tomu, aby
reparační mechanismy odstranily duplikaci a zvětšené varianty
proteinu p53 vymizely. Proto jsme westernovým přenosem detekovali
pouze protein p53 o standardní molekulové hmotnosti (obr.
4b).
Funkční analýza v kvasinkách se často používá
pro analýzu statutu p53 a všeobecně se pokládá za velmi
spolehlivou. Prezentovaný kuriózní příklad naznačuje možná omezení
pro použití kvasinkových buněk pro analýzy lidského genu p53.
Ukázali jsme, že některé mutace p53 mohou být v kvasinkách
nestabilní. Na druhou stranu, samotná metoda přítomnost
inaktivující mutace p53 jednoznačně prokázala, a to
reprodukovatelně, a bizarní morfologie kvasinkových kolonií dokonce
naznačila její neobvyklou povahu. Tyto výsledky proto poskytují
další důkaz, že FASAY je skvělá metoda pro funkční analýzy p53.
Poděkování
Práce je podporována grantem NR/9305-3 IGA MZ ČR a MŠM
0021622415.
Reference
- H. G. Drexler, S. Fombonne, Y. Matsuo, Z.B. Hu, H. Hamagichi,
C. C. Uphoff. p53 alterations in human leukemialymphoma cell lines:
in vitro artifact or prerequisite for cell immortalization?,
Leukemia 14 (2000) 198-206.
- J. M. Flaman, T. Frebourg, V. Moreau, F. Charbonnier, C.
Martin, P. Chappuis, A. P. Sappino, J. M. Limacher, L. Bron, J.
Benhattar, M. Tada, E. G. Van Meir, A. Estreicher, R. D. Iggo. A
simple p53 functional assay for screening cell lines, blood, and
tumors, Proc. Natl. Acad. Sci. USA 92 (1995) 3963-3967.
- P. Hainaut, M. Hollstein. p53 and human cancer: The first ten
thousand mutations, Adv. Canc. Res. 77 (2000) 81-137.
- C. Ishioka, T. Frebourg, Y.X. Yan, M. Vidal, S. H. Friend, S.
Schmidt, R. Iggo. Screening patients for heterozygous p53 mutations
using a functional assay in yeast, Nat. Genet. 5 (1993)
124-129.
- A. J. Levine, W. Hu, Z. Feng. The p53 pathway: what questions
remain to be explored?, Cell Death Differentiation 13 (2006)
1027-1036.
- M. S. Lindstrom, K.G. Wiman. Role of genetic and epigenetic
changes in Burkitt lymphoma, Semin. Cancer. Biol. 12 (2002)
381-387.
- R. Nenutil, J. Smardova, S. Pavlova, Z. Hanzelkova, P. Miller,
P. Fabian, R. Hrstka, P. Janotova, M. Radina, D. P. Lane, P. J.
Diates, B. Vojtesek. Discriminating functional and non-functional
p53 in human tumours by p53 and MDM2 immunohistochemistry, J.
Pathol 207 (2005) 251-259.
- M. Olivier, R. Eeles, M. Hollstein, M. A. Khan, C. C. Harris,
P. Hainaut. The IARC TP53 Database: new online mutation analysis
and recommendations to users, Hum.Mutat. 19 (2002)
607-614.
- M. Olivier, S. P. Hussain, C. C. de Fromentel, P. Hainaut, C.
C. Harris. TP53 mutation spectra and Load: A tool for generating
hypotheses on the etiology of cancer, IARC Sci Publ. 157 (2004)
247-70.
- A. Petitjean, M. I. W. Achatz, A.L. Borresen-Dale, P. Hainaut,
M. Olivier. TP53 mutations in human cancers: functional selection
and impact on cancer prognosis and outcomes, Oncogene 26 (2007)
2157-2165.
- J. Smardova, A. Nemajerova, M. Trbusek, V. Vagunda, J. Kovarik.
Rare somatic p53 mutation identified in breast cancer: A case
report, Tumor Biol. 22 (2001) 59-66.
- J. Smardova, S. Pavlova, M. Svitakova, D. Grochova, B.
Ravcukova. Analysis of p53 status in human cell lines using a
functional assay in yeast: Detection of new non-sense p53 mutation
in codon 124, Oncology Rep. 14 (2005) 901-907.
- T. Soussi, B. Asselain, D. Hamroun, S. Kato, C. Ishioka, M.
Claustres, C. Beroud. Meta-analysis of the p53 mutation database
for mutant p53 biological activity reveals a methodological bias in
mutation detection, Human Cancer Res. 12 (2006) 62-70.
- M. Trbusek, J. Malcikova, J. Smardova, V. Kuhrova, D.
Mentzlikova, H. Francova, S. Bukovska, M. Svitakova., P. Kuglik, V.
Linkova, M. Doubek, Y. Brychtova, J. Zacal, J. Kujickova, S.
Pospisilova, D. Dvorakova, J. Vorlicek, J. Mayer. Inactivation of
p53 and deletion of ATM in B-CLL patients in relation to IgVH
mutation status and previous treatment, Leukemia 20 (2006)
1159-1161.
- M. Trkova, L. Torerova, R. Kodet, P. Hedvicakova, Z. Sedlacek.
A Li-Fraumeni syndrome family with retained heterozygosity for a
germline TP53 mutation in two tumors, Cancer Genet. Cytogenet 145
(2003) 60-64.
- Y. Yang, C.C.H. Li, A.M. Weismenn. Regulating the p53 system
through ubiquitination, Oncogene 23 (2004) 2096-2106.
- M. Wilda, J. Bruch, L. Nardet, D. Rawer, A. Reiter, A. Borkhardt, W. Woessmann. Inactivation of the ARF-MDM- 2-p53 pathway in sporadic Burkitt’s lymphoma in children, Leukemia 18 (2004) 584-588.
Legendy
Obr. 1: Analýza nádorové tkáně.
Mikroskopický snímek řezu nádorové tkáně po obarvení hematoxylinem vykazuje typický obraz „hvězdného nebe“.
Obr. 2: Určení hladiny proteinu p53 v nádorové tkáni.
(a) Imunohistochemická detekce proteinu p53 v nádorové tkáni
s využitím monoklonální protilátky DO-7.
(b) Proteinový extrakt z buněk kontrolní linie odvozené z
lidského karcinomu prsu (1, pozitivní kontrola) a nádorové tkáně
(2) byl rozdělen SDS-PAGE a buď analyzován westernovým přenosem
(horní část) nebo obarven Coomassie brilliant blue (spodní
část).
Obr. 3: Funkční analýza separovaných alel v
kvasinkách.
(a) cDNA standardního (1) a nádorového p53 (2) amplifikovaná
RT-PCR připravená pro transformaci kvasinkových buněk byla
rozdělena agarózovou gelovou elektroforézou a obarvena ethidium
bromidem.
(b Morfologie kvasinkových kolonií ilustruje výsledky FASAY
po třech a pěti dnech kultivace: směs bílých (6,8%), červených
(4,0%) a „skvrnitých“ kolonií (89,2%). Vlevo dole je dokumentován
charakter „skvrnitých“ kolonií při větším zvětšení.
Obr. 4: Analýza stavu p53 ve „skvrnitých“ kvasinkových
koloniích.
(a) cDNA p53 čtyř kolonií transformovaných kvasinek (’1 - 4)
po amplifikaci PCR. Jako kontrola byly použity kvasinkové buňky
exprimující standardní typ cDNA p53 (WT) a produkt RT-PCR odvozený
z nádorové tkáně (TT).
(b) Proteinové extrakty připravené ze dvou kvasinkových
kolonií byly rozděleny SDS-PAGE a buď analyzovány westernovým
přenosem monoklonální protilátkou DO-1 (horní část) nebo obarveny
Coomassie brilliant blue (spodní část). Jako pozitivní kontrola
byly použity kvasinkové buňky exprimující standardní p53 (WT).
Obr. 5: Nukleotidová sekvence cDNA p53 odvozené z nádorové
tkáně.
Čísla nad nukleotidovou sekvencí označují pořadí nukleotidů v
genomové DNA (GeneBank), čísla pod sekvencí udávají pořadí kodónů v
cDNA.
Obr. 6: Ztráta p53 specifického lokusu detekovaná pomocí
FISH.
Mikroskopické preparáty byly připraveny z formol-parafinových
bločků testované tkáně standardním postupem. Hybridizaci se sondou
LSIp53 specifickou pro lokus p53 17p13 (oranžový signál) a
centromerickou sondou CEP 17 (zelený signál) jsme sledovali
fluorescenční mikroskopií.
Obr. 1
Obr. 2

Obr. 3a

Obr. 3b
Obr. 4

Obr. 5

Obr. 6

Datum přednesení příspěvku: 12. 10. 2007
